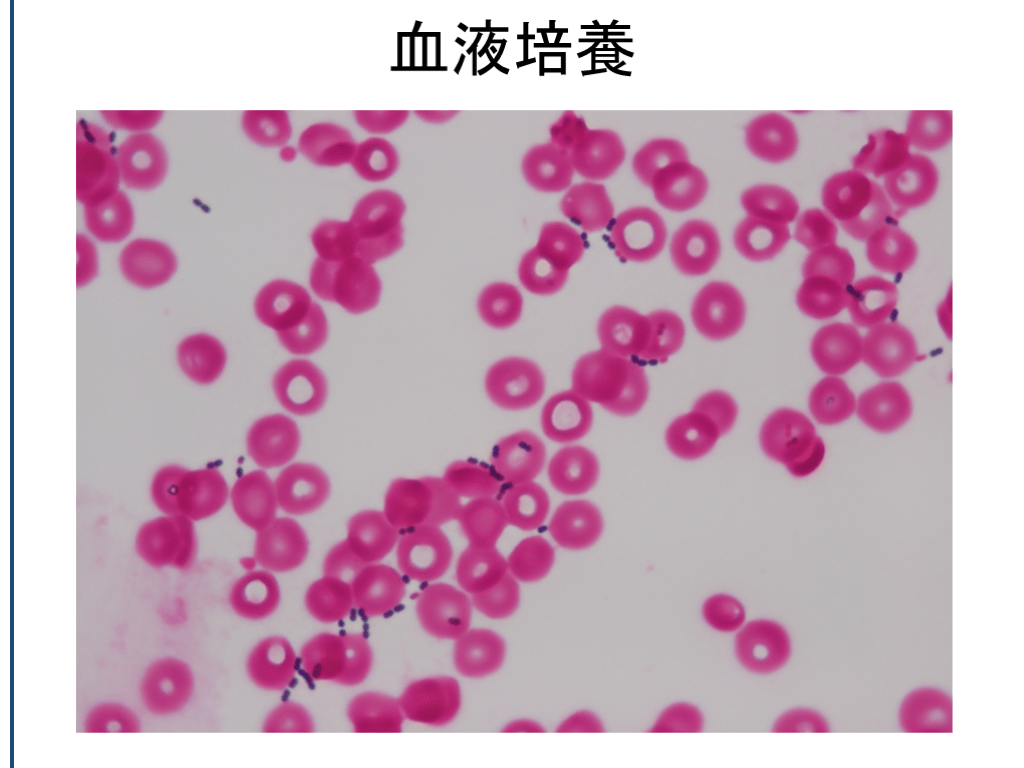

1/41
関連するスライド
発熱・不明熱へのアプローチ
379,415
575
概要
不明熱を含めた発熱へのアプローチについて、全般的な視点や優先順位を身につける。さらにさまざまな状況に応じた発熱の鑑別リストを学習する。初期研修医向け
本スライドの対象者
研修医/専攻医
投稿された先生へ質問や勉強になったポイントをコメントしてみましょう!
0 件のコメント
島田利彦さんの他の投稿スライド
すべて見るこのスライドと同じ診療科のスライド
テキスト全文
発熱と不明熱の基本概念
#1.
Essential & effortless発熱と不明熱 2022/5/11 淡海医療センター
#2.
ダメ!ゼッタイ?薬物乱用 耐性菌 コスト 薬剤副作用 診断エラー 実際は状態によるのですが
#3.
62歳男性 嘱託勤務 入院前日から節々の痛み、悪寒と嘔吐あり。改善せず高熱がでたため救急受診 周囲の人に発熱など異常なし (4月) 上気道・下気道症状なし 腹痛や下痢なし 嘔吐は一回のみで持続的な嘔気なし 熱のせいか、尿は少し出づらいようにも思う
62歳男性の症例と評価
#4.
既往:20年前に膵がんで尾部切除 以来DMでインスリン加療(HbA1c 6台) 高血圧あり 飲酒:ビール500ml/日以上 喫煙なし
#5.
108/64mmHg, p 118/min, BT 38.6℃ 身体所見上、あきらかな異常なし WBC 24890, CRP 13.5, BS 217mg/dl 尿糖 4+, 尿ケトン 2+, 尿沈査異常なし インフルエンザ迅速検査:陰性 *Covid pandemic前 胸部レントゲン 異常なし 胸腹部CTに大きな問題なし
#6.
What to do next ?62歳 元気な糖尿病男性熱源の特定できない急性発熱 どう評価する? Dispositionは?
不明熱の定義と重要性
#7.
発熱 視床下部の体温調節中枢機能の変調から,熱の産生と放散のバランスが乱れ,平常値よりも体温が上昇を示す現象をいう。 高体温とは区別が必要
#8.
不明熱 FUO Petersdorf らによる古典的な不明熱の定義 「38.3 度以上の発熱が何度か認められる状態が 3 週間を超えて続き,1 週間の入院精査でも原因が不明のもの」 感染症、悪性腫瘍、膠原病 現場でのいわゆる‘不明熱’は真の不明熱ではない‥ どうして3週間以上なの?2週間ではだめ? 古典的ってどういうこと?
#9.
FUOヘテロな概念であり、時代とともに変わる
#10.
不明熱を特別扱いする前に
発熱の大原則とアプローチ
#11.
発熱の大原則 ID or not ID × focus
#12.
熱の大原則 「 感染か否か × focus 」 すべての診断は 「原因×解剖・臓器」 発熱・不明熱でも同じコト 急性発熱では、感染症の可能性が高い 3週間以上なら、非感染症の可能性が高い 6ヶ月以上ならさらに感染症らしくない 特に治療可能な細菌感染なら住処があるはず = focusの検索を徹底する
#13.
「不明熱 → 感染症・悪性腫瘍・膠原病」の一歩先
#14.
発熱・不明熱 アプローチ 1ID 感染症 細胞外(細菌) Top to bottom approach ‘primary survey’ 問診と診察で、focusを頭から足までスキャン そもそも全身をチェックしないで“不明熱”というのはやめよう 細胞内 (Virus, 粟粒結核, Mycoplasma, Rickettsia etc ) focusがわかりにくい、あるいは全身。 検査でも捕まえにくい。 → 病歴聴取によるリスク評価が重要な武器 (後述)
感染Focusの検索とリスク評価
#15.
Focus検索のコツ 盲点‘Secondary survey’ 深頚部・血管内・骨関節・後腹膜・骨盤 1. 特に高齢者で見落とされがちな部位* 2. CTのカバー範囲外 * 口腔周囲 * 骨盤周囲: 生殖器、褥瘡 * 四肢: 皮膚・ 関節 寝たきりおばあちゃんの靴下をめくると蜂窩織炎
#16.
70歳台 脊損で寝たきり 発熱で救急搬送 胸部レントゲン、尿検査に問題なし 両側の大腿後面に発赤と熱感ありと報告あり 蜂窩織炎?として入院 翌日臀部を見ると‥ (筋膜炎ではなかったですが‥) 例えばこんなのも
#17.
感染Focusの検索血液培養から逆算することも S.aureus S.dysagalactiae Bacteroides Bacillus cereus Coxiella burnetii Strep. gallolyticus IE, 皮膚, 骨髄 蜂窩織炎 腹腔内 カテーテル感染 IE IE+大腸癌 Focusを探し切れていない可能性も踏まえて、とれる培養はとっておく
#18.
病歴:リスク評価 環境: 市中発生 vs. 院内発生 解剖と免疫状態: 既往歴、 薬歴(ワクチン含む)、 デバイス、 手術歴 Sick contact: 発熱や急病の人が周囲にいたか TB contact: 結核またはその疑い例が周囲にいたか Sexual contact: 性行為の有無 Travel history: 海外渡航歴 travelers‘ fever Animal contact: 動物の接触歴
非感染症による発熱のアプローチ
#19.
免疫のインスタント評価 解剖学的異常 (手術含む) 好中球減少 細胞性免疫不全 液性免疫不全
#20.
好中球減少性発熱Febrile neutropenia / Neutoropenic fever 意識して探すべきフォーカス:AIUEOS Anal Indwelling catheter Upper GI Eye Oral Skin, sinus 皮膚は小病変でも生検や培養を
#21.
感染症の原則 症候群 focus・source 薬剤師 細菌検査技師 医師
#22.
発熱・不明熱 アプローチ2Non ID 非感染症 まず薬剤 !! Malignancy; 熱が出やすい悪性腫瘍: 固形癌では頻度少ない ・ 血液悪性腫瘍 悪性リンパ腫(IVL etc.), 白血病 ・ RCC: Internist tumorの別名 ・ HCC など メモ: 多発性骨髄腫では発熱は少ない No fever, No splenomegaly No ALP elevation
特別な発熱の状況と評価
#23.
発熱・不明熱 アプローチ2Non ID 非感染症 Non infectious inflammatory disorder; Rheumatologic, vasculitis, and granulomatous disease 1. 発熱しやすい疾患 vs. 発熱しにくい疾患 ○: SLE, AOSD, 血管炎, 結晶性関節炎 ×: 関節リウマチ, SjS, 強皮症 2. 小血管炎(ANCA etc.)はどこかにfocus/臓器障害がある 3. 大~中血管炎の診断が難しい(PAN, GCA, Takayasu) 4. 激レア疾患もありますけど‥(家族性地中海熱 etc.) RA単独では発熱少ない 末梢関節痛+発熱でRAだけということはない 血管炎や感染の合併を疑う
#24.
発熱・不明熱 To do lists(案) 全身のROS, 診察 focus探索 患者背景, 免疫状態などのリスク評価 発熱以外の徴候はないか? 皮疹・リンパ節など 薬剤の見直し・中断 ルーチン検査 Pan-culture 特にB/C×2 (抗生剤なしで) CBC 分画 , Chemistry (LDH), CRP, ESR, U/A CXP, 胸腹部CT(造影) ANA, フェリチン 〈 sIL2R, TFTs, ANCA, IGRA〉 RF/ACPA [注意すること] 生検すべき組織はないか? Tissue is issue 詐熱, VB12欠乏, 肺塞栓, DVT,内分泌(甲状腺や副腎不全), 大動脈解離, 血腫の吸収熱, 無汗症など稀な疾患
#25.
ここまで評価してなにもなければ 予後良好のはずなので、バイタルに注意して我慢 「何らかのウイルスの可能性が高く、自然治癒が期待できます。 ただし発熱自体は2-3週間位は続くかもしれません」
#26.
Flu like syndrome / Viral syndrome/Influenza like illness 高熱のみで(フォーカスに乏しい)急性熱性症候群 Covid19, インフルエンザ 腎盂腎炎, 前立腺炎 高齢者では無症候性細菌尿も多く、症状・身体所見にも乏しいためわかり にくい。悪寒戦慄や嘔吐は菌血症を示唆する。 キャンピロバクタ―腸炎 若年者で悪寒戦慄を伴う高熱 + 翌日に下痢 Pontiac fever レジオネラ ODTS 有機粉塵による過敏性肺臓炎の亜型 TSS 発熱・筋痛 +結膜炎、下痢、紅斑、ショック
入院患者での発熱リスト
#27.
特別な発熱の状況院内発症の発熱を中心に(当然、医療行為と関連が多い)発熱と皮疹発熱とリンパ節腫脹海外旅行帰りの発熱:等は別の機会に
#28.
1-1. 入院患者での発熱リスト 院内発熱の5~7D Drug 入院患者の発熱の5%前後(好酸球・比較的徐脈・皮疹) Difficile De痛風 Device Decubitus ulcer 褥瘡 DVT Dressler (心筋梗塞後) Debris (胆嚢炎)やdeep abscessなど 入院後48時間以降の発熱 自分なりのチェックリストを用意しておく
#29.
1-2. 入院患者での発熱リスト 院外発症よりも感染症が多い 薬剤熱 DVT/PE Catheter感染(末梢静脈炎、転移性のIEにも注意) PMC (偽膜性腸炎、CD associated enterocolitis) 血腫(後腹膜) 肺炎(誤嚥性肺炎、VAP) SSI/ postcardiotomy 複雑性尿路感染 褥創(からの骨髄炎) 副鼻腔炎・中耳炎(挿管されている患者) 中枢性の熱(高体温) 無石性胆嚢炎(TPNの患者) 内分泌(thyroid storm/ adrenal insufficiency)
#30.
1-3. 入院患者での発熱リスト ~ ICU Infected intravascular catheter Sinusitis or otitis media (in pts with intranasal devices) Acalculous cholecystitis Drug fever PE / DVT Hematoma Central fever (in pts with head trauma) CD colitis Postcardiotomy syndrome Secondary infection by resistant organism / fungal infection
CRPの上昇しない発熱の考察
#31.
2. 抗生剤開始後も遷延する発熱 そもそも感染症ではない (薬剤性など) 【さらに4つのDを確認】 薬剤が届かない delivery 血流不全/臓器 耐性やスペクトラム外 drug resistance 膿瘍形成・外科的介入が必要 debris/drainage 薬剤の量が足りない dosage
#32.
症例: 20歳代男性 交通事故による硬膜下血腫・SAHで緊急搬送 緊急血腫除去手術行うが、以降混迷状態続く 入院2週後から40℃を超える高熱が継続、メロペネムに反応なし 肺炎なし 尿路感染なし 下痢なし 末梢カテーテル発赤なし WBC 5200, CRP 0.1 血液培養は複数回陰性 抗けいれん薬を中止するが、解熱せず カルバペネム無効、炎症反応の上昇しない院内発熱
#33.
3. CRPの上昇しない発熱/高体温 髄膜炎/髄膜脳炎 (症例はMRSAによる髄膜脳室炎) SLE ウイルス感染症 末期肝不全 薬剤性 副腎不全、甲状腺機能亢進症 VB12欠乏やVB12補充開始後の発熱 熱中症(高体温) 視床熱などの中枢性発熱 被包化された膿瘍 うつ熱: 無汗症・コリン性蕁麻疹 抗コリン薬 詐熱 抗IL6抗体投与患者
#34.
メモ: CRPが上昇しない炎症性疾患 基本的には熱性疾患ではない疾患 ・ Sjogren ・ IgG4RD (炎症性動脈瘤は別) ・ 乾癬性関節炎(40%程度しか上がらない) ・ Scleroderma ・ HES (CSSとの鑑別点)
発熱の初動と重要ポイント
#35.
最初の症例は
#36.
血液培養
#37.
OPSI・侵襲性肺炎球菌感染症 膵がんの手術時に脾臓摘出を受けていた! 脾臓摘出後重症(肺炎球菌)感染症 Overwhelming post-splenectomy infections : Post Splenectomy Sepsis (PSS) 薬・手術・処置歴のある患者では、まずそこから!
#38.
免疫の評価(改変再掲) 解剖学的異常 (手術含む) 好中球減少 液性免疫不全:免疫グロブリン 細胞性免疫不全:T細胞 無脾・脾機能低下 補体低下・欠損
#39.
Take home points ‘発熱の初動’ 感染症か? 非感染症か? Top to bottomでfocusさがし 免疫・解剖と曝露のリスク評価 血液培養 + Pan-culture 状態次第では広域抗生剤
#40.